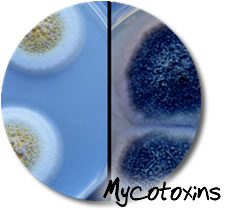
news-image

Technical
Through our technical news forum, customers are kept up-to-date with latest industry developments and management advice.
Managing Moulds and Mycotoxins in Poultry Feeds
Managing Moulds and Mycotoxins in Poultry FeedsThe term “mycotoxin” is derived from myco meaning fungi and toxin, a poison; hence, the word literally means poisons from fungi. There are more than 300 known mycotoxins, but very little is known about the relative toxicity of most of these compounds. The fungi that produce mycotoxins can infect and produce mycotoxins in cereal grains such as corn and sorghum in the field ... Read more
 Poultry Nutrition and Management
Poultry Nutrition and ManagementThe science of nutrition involves providing a balance of nutrients that best meets the animals needs for growth, maintenance, egg production, etc. For economic reasons, this supply of nutrients should be at least cost, and so we must supply only enough for requirements, without there being any major excesses. It is very difficult and very expensive to supply... Read more
 Swine Health through Nutritional Integrity and Feed Safety
Swine Health through Nutritional Integrity and Feed SafetyUnder the conditions of modern swine production, pigs need to be fed a balanced diet that meets their daily nutritional requirement for maintenance, growth, and reproduction. However, nutrient intake is largely determined by voluntary feed intake, which is greatly infl uenced by the chemical senses of olfaction and taste. Thus, it is essential to make sure that diets being offered to pigs are highly... Read more
Our services
We deliver Total Consultancy Solutions across 2 platforms:
Management Solutions
We focus on the 2 principal areas of tactical and strategic business management. View more
Biotechnology Solutions
Sustainable profitable agriculture is essential to meet the food demands of the growing world population. Effective biotech applications are critical. View more








